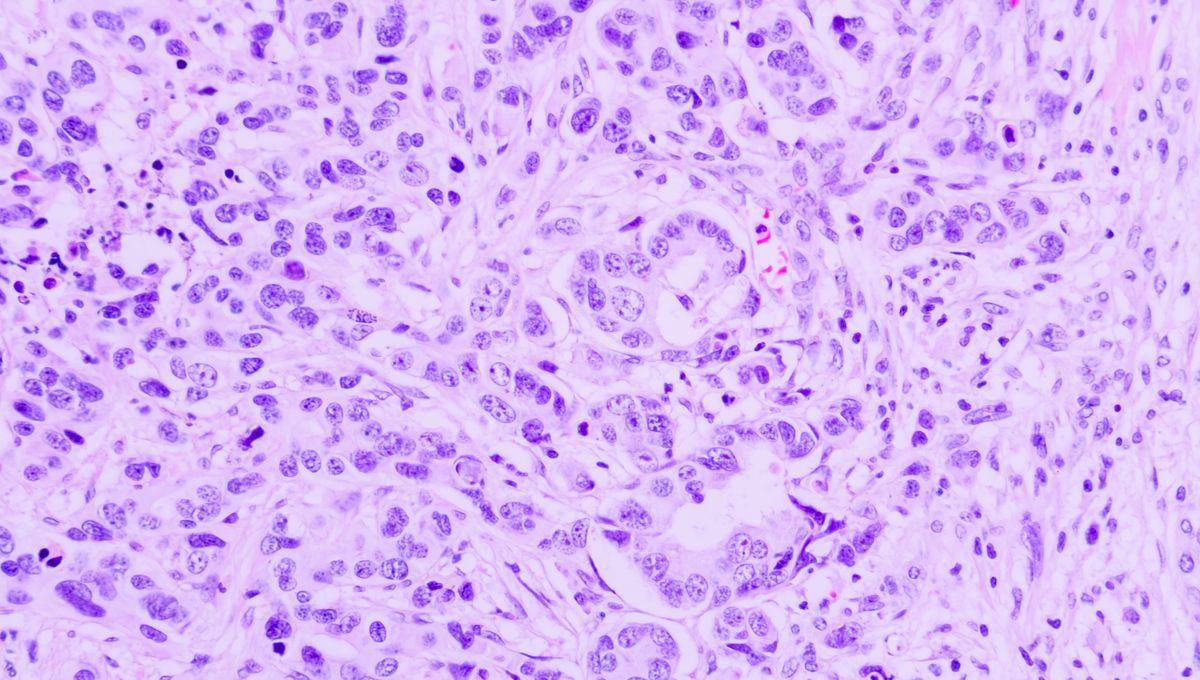
Feed Image

IFLScience
shared a link post in group #IFLScience

www.iflscience.com
The “Third State” That Lies Beyond The Boundaries Of Life And Death
This challenges our understanding of life, death, and the nature of organisms.

IFLScience

shared a link post in group #IFLScience
www.iflscience.com
The “Third State” That Lies Beyond The Boundaries Of Life And Death
This challenges our understanding of life, death, and the nature of organisms.
Comment here to discuss with all recipients or tap a user's profile image to discuss privately.
<div data-postid="xbmanao" [...] </div>